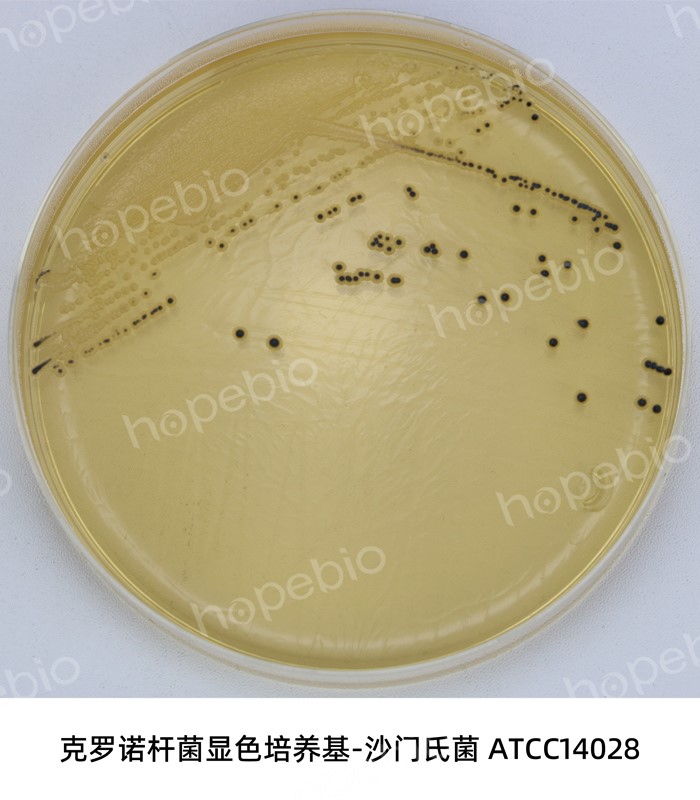

海博微信公众号
海博微信公众号
 海博天猫旗舰店
海博天猫旗舰店


 海博微信公众号
海博微信公众号
 海博天猫旗舰店
海博天猫旗舰店




在微生物的隐秘王国里,某些细菌如同披着伪装的刺客,时刻威胁着人类健康。这些微小生物通过精密的致病机制,能够突破人体防线引发严重疾病。现代医学研究已明确约200种致病菌对人类构成直接威胁,其中约30%具有致命风险。这些病原体通过空气、食物、接触等渠道无声渗透,在人体内构建起致命的生物工厂。
一、食物中的隐形杀手
金黄色葡萄球菌(如图1所示)在常温下只需3小时即可在乳制品中产生致命肠毒素,其产生的耐热性毒素即使用100℃高温处理30分钟仍保持毒性。2018年韩国集体食物中毒事件中,该菌在速食紫菜包饭中导致287人急性胃肠炎。沙门氏菌(如图2所示)展现更强环境适应性,能在干燥环境中存活数周,2015年美国黄瓜污染事件引发9个州642人感染。肉毒杆菌在无氧环境中产生的神经毒素,0.1微克即能致死,家庭自制的豆豉、臭豆腐成为主要风险源。

图1 金黄色葡萄球菌在金黄色葡萄球菌显色培养基(第二代)上的菌落特征
图2 沙门氏菌ATCC 14028在克罗诺杆菌显色培养基上的菌落特征
这些食源性病菌通过破坏肠上皮细胞紧密连接蛋白,诱发肠粘膜屏障崩溃。最新研究发现,某些菌株能劫持宿主细胞信号通路,促使细胞骨架重组,加速病原体扩散。
二、水源传播的致命威胁
霍乱弧菌(如图3所示)通过鞭毛运动穿透肠粘液层,其分泌的霍乱毒素激活腺苷酸环化酶系统,导致肠上皮细胞氯离子通道持续开放。2010年海地霍乱大流行造成82万人感染,死亡近9800人。产志贺毒素大肠杆菌O157:H7通过III型分泌系统注入效应蛋白,诱发肠出血症状,首次发现大肠杆菌O157:H7是在美国俄勒冈州的一次汉堡肉饼中毒事件中,当时47人因食用受污染的牛肉而患病,其中两名儿童不幸身亡。

菌落扁平湿润,中心黑色,直径2-3mm
图3 霍乱非O1弧菌在四号琼脂上的菌落特征
三、呼吸道入侵者
结核分枝杆菌运用蜡质细胞壁抵抗巨噬细胞溶酶体杀伤,通过ESX-1分泌系统逃逸吞噬体。世界卫生组织数据显示,2021年全球新发结核病例1060万例,耐药菌株占比持续上升。肺炎链球菌表面多糖荚膜抑制补体沉积,其分泌的肺炎溶素形成跨膜孔道溶解红细胞,每年导致200万5岁以下儿童死亡。
四、创伤感染的危险分子
破伤风梭菌在深部伤口中产生破伤风痉挛毒素,其重链特异性结合神经元神经节苷脂,轻链作为锌内肽酶切割突触小泡蛋白。全球每年约20万新生儿因脐带感染死亡。炭疽杆菌通过三组分毒素破坏宿主免疫细胞:保护性抗原介导内吞,致死因子切割MAPKK,水肿因子催化cAMP超载。
这类创伤相关病原体形成芽孢抵抗极端环境,炭疽芽孢在土壤中可存活数十年。最新疫苗研发聚焦重组保护性抗原表位,同时针对毒素和芽孢设计双效抗体。
五、结语
面对这些微观世界的致命杀手,现代防御体系需要多维度构建。除常规灭菌消毒外,应建立基于全基因组测序的病原体监测网络,开发CRISPR-Cas介导的精准抗菌疗法。个人防护需强化冷链食品管理、伤口及时清创等预防意识。微生物学家正在研发噬菌体鸡尾酒疗法,针对耐药菌进行特异性裂解,这或许将开启抗感染治疗的新纪元。(本公司有培养上述菌种的相关培养基,详情请见表1)
表1 青岛海博生物相关产品信息
|
产品编号 |
产品名称 |
规格 |
产品说明及用途 |
|
HB7009-5 |
1000ml |
用于金黄色葡萄球菌的显色培养,金黄色葡萄球菌显紫红色 |
|
|
HB4115 |
250g |
用于金黄色葡萄球菌的选择性分离培养 (GB、FDA、ISO、SN标准) |
|
|
HB4119 |
250g |
用于金黄色葡萄球菌的选择性增菌培养(GB标准) |
|
|
HB4087 |
250g |
肠道菌选择性培养基,特别是沙门氏菌的选择性分离 (GB、SN标准) |
|
|
HB4089 |
250g |
用于沙门氏菌,志贺氏菌的选择性分离培养 (GB标准) |
|
|
HB4129 |
250g |
用于霍乱弧菌选择性增菌培养 |
|
|
HB4133-2 |
250g |
用于霍乱弧菌的分离培养(GB标准) |
|
|
HBPT001-9 |
50支/盒 |
适用于百日咳、白喉、脑膜炎奈瑟菌、流感嗜血杆菌、肺炎链球菌等呼吸道细菌的保存 |
|
|
HBPT001-12 |
1.4ml*50支/盒 |
用于肺炎链球菌的采集、转运和保存 |
|
|
HB6255 |
250g |
用于炭疽杆菌的培养及初步鉴定 |
|
|
HB6257 |
250g |
用于炭疽杆菌的分离鉴别 |
注:本文属海博生物原创,未经允许不得转载。
下一篇:没有了!
| 相关文章: | |



